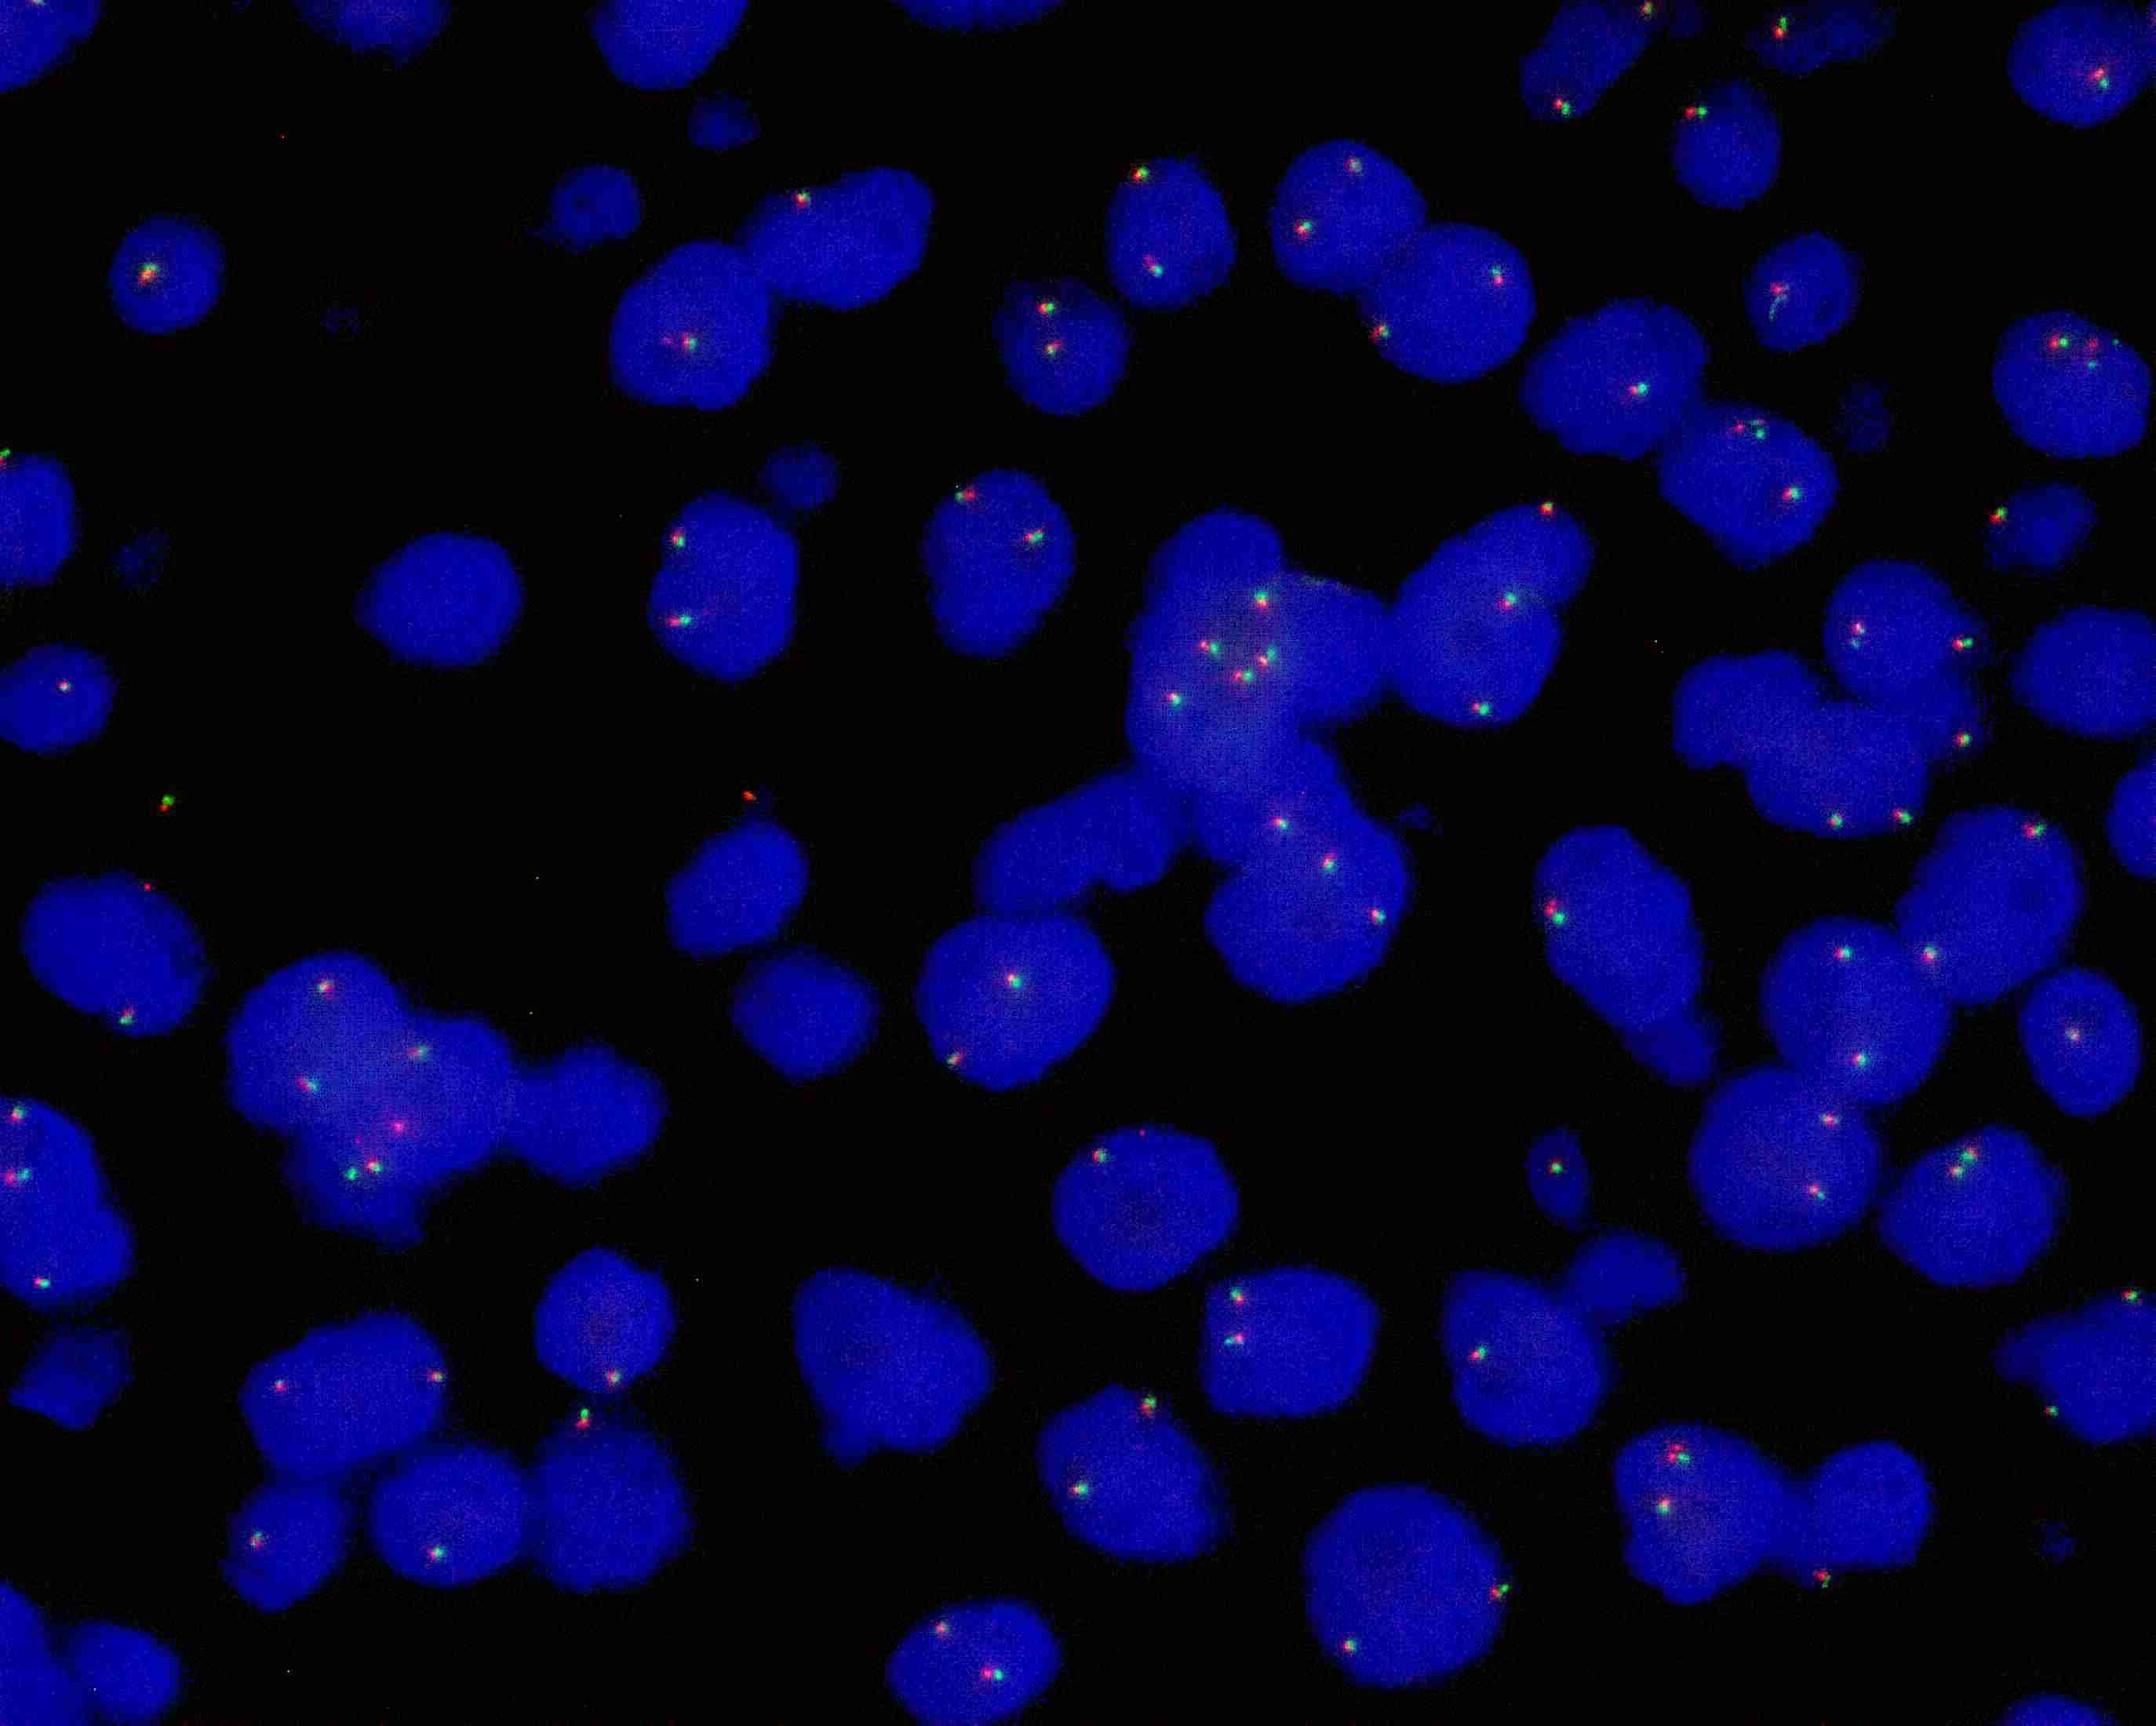
FP-075

TFE3 gene break apart probe reagent
SKU: FP-075
TFE3 gene break apart probe reagent
Regular,in stock
TFE3 dual color probe
Description:
TFE3 gene 3’ end labeled as orange, with a length of 585 kb; TFE3 gene 5’ end labeled as green, with a length of 583 kb.
Reference:
Expert Consensus on Advances in Molecular Pathology and Testing of Renal Cell Carcinoma (2020 Edition) Sci Rep. 2016;6:21677. Pathol Oncol Res. 2021;27:610360. Pathologe. 2021;42(3):310-318. Am J Surg Pathol. 2020;44(7):e47-e65. Mod Pathol. 2020;33(4):591-602.